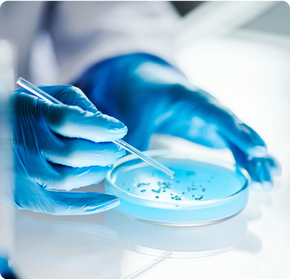
Microbiome Therapeutics

What is Decode Biome Test
Decode Biome is a comprehensive microbiome testing and analysis platform. It offers detailed insights into gut health, supporting personalised care and better outcomes.
✓ Plug-and-play setup
✓ End-to-end testing and reporting
✓ Fast turnaround time (shortest in India)
✓ Over 5000+ data points processed
✓ Accurate, research-grade sequencing
✓ Optional API support for large-scale integrations


How It Works
We use Advanced Whole Metagenome Sequencing to analyse the gut microbiome at the species level.
What this means for you:
Accurate insights into key microbial communities
Reliable results, based on advanced research methods
Simple reports, easy to read and act on
Safe and certified testing, done in our own NGS lab
Who It's For
Clinicians & Clinical Researchers
Enhance patient care with precise microbiome data.
Research Institutes
Access robust tools for microbiome studies.

Preventive Healthcare Practitioners
Support clients' longevity journeys with informed diagnostics.
Holistic Healthcare Companies
Integrate cutting-edge microbiome analysis into your offerings.
Ongoing Microbiome Studies at Decode Age Lab

The ZuGrama Experiment
A one of kind, community driven, and environmentally controlled study on the effect of short-term dietary intervention on microbiome profiles.

Metabolites Targeting Pathways of Ageing
An interdisciplinary computational biology project identifying and simulating how metabolites of the human microbiome interact with pathways, genes, and mechanistic targets of ageing.

IBS Study
A collaborative study exploring the role of the microbiome’s potential in regulating inflammation and gut-brain axis.
Microbiome Therapeutics
A pre-clinical spin-off project with IISc/FSID that focuses on microbiome therapeutics on rejuvenation.
Benefits of Decode Biome Test
Frequently Asked Questions
What services does Decode Biome offer to businesses and research institutes?
Decode Biome provides comprehensive microbiome analysis services, including taxonomic profiling, functional potential analysis, biomarker discovery, and custom research. Our platform is designed to help businesses and research institutions conduct reliable, reproducible studies.
How does Decode Biome benefit my research or healthcare organization?
By integrating Decode Biome into your operations, your organization gains access to cutting-edge technology that ensures precise and robust microbiome analysis. Our platform supports research in areas like ageing, cancer therapy, IBS, and microbiome therapeutics, providing valuable insights that drive clinical decisions and innovative treatments.
How do I get started with Decode Biome for my B2B needs?
Getting started is easy! Simply contact us via email at biome@decodeage.com or book a meeting through our website. Our team will walk you through our services and help you integrate microbiome analysis into your business or research processes.
What industries can benefit from partnering with Decode Biome?
Healthcare providers and clinicians can enhance diagnostic accuracy and personalize patient care using microbiome insights. Holistic healthcare companies can integrate microbiome data to develop personalized health solutions for their clients. Research institutions can conduct cutting-edge studies in aging, aging-related diseases, and microbiome therapeutics. Pharmaceutical and biotechnology companies can leverage microbiome data for drug development, cancer research, and therapeutic innovations.
How long does it take to receive results from Decode Biome?
We offer one of the fastest turnaround times in the industry, with results typically delivered within 21-23 days. This ensures that you can move forward with your research or clinical decisions promptly.
What sets Decode Biome apart from other microbiome analysis platforms?
Our platform offers end-to-end solutions from wet lab to dry lab, ensuring reliable and reproducible results. We provide in-depth analysis, including taxonomic profiling, functional potential, and biomarker discovery. With a fast turnaround time of 21-23 days and extensive mock validation, we ensure the highest quality data for your needs. We work with global leaders and passionate teams, ensuring that our research remainscutting-edge and aligned with the latest industry advancements.
How do we collaborate with Decode Biome for a custom project?
To start a custom project, reach out to us with your specific needs. We can provide tailored solutions for your research or clinical requirements, leveraging our proprietary analytics engine and vast microbiome database.
Is Decode Biome's technology compatible with my organization's existing systems?
Yes, Decode Biome is designed to be a plug-and-play platform, making it easy to integrate with your organization’s existing systems, whether in research or clinical practice. We provide full support to ensure seamless integration and data compatibility.
What makes Decode Biome’s data so reliable for business decisions?
Our platform delivers high-fidelity, reproducible data through extensively validated wet and dry lab protocols. With over 5,000 Indian-specific microbiome profiles, we ensure population-relevant insights that are accurate, standardised, and ready to drive data-backed decisions in healthcare and research.
Are there any partnership opportunities with Decode Biome?
Yes, we actively collaborate with businesses and research organizations to drive innovation in microbiome research. Whether you’re a healthcare provider, researcher, or a biotech company, we offer partnership opportunities to co-develop solutions and expand your research capabilities.
How does Decode Biome ensure data privacy and confidentiality?
We take data security seriously. All data processed through Decode Biome is handled according to strict privacy and confidentiality standards, complying with the latest regulations in data protection.
Can Decode Biome be used for clinical applications?
Yes, our platform is suitable for clinical applications. We provide microbiome analysis that supports clinical decisions, particularly in personalized medicine, preventive healthcare, and therapeutic interventions for age-related diseases.














